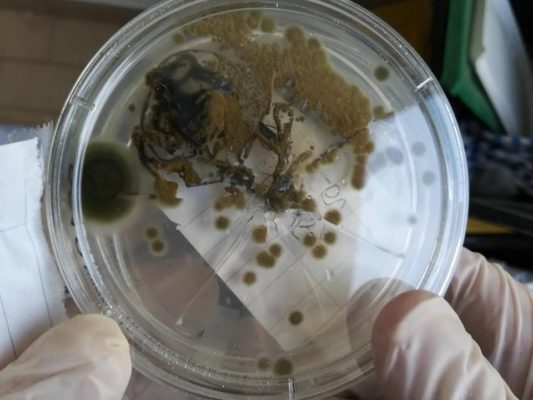

Come eliminare la muffa: i metodi più utilizzati
Per tutti coloro che vivono in case con problemi di umidità è fondamentale comprendere come eliminare la muffa dai muri in via definitiva. Questo infatti

Per tutti coloro che vivono in case con problemi di umidità è fondamentale comprendere come eliminare la muffa dai muri in via definitiva. Questo infatti
Si fa un gran parlare di muffa in casa e spesso la vediamo in giro su mura, cibo, terra e altre superfici. Ma sappiamo esattamente
Stai cercando qualcosa in particolare?
Fai una ricerca oppura visita le categorie
ACCETTAZIONE E RINUNCIA DEI COOCKIE
Proseguendo nella navigazione su questo sito, chiudendo la fascetta informativa o facendo click in una qualsiasi parte della pagina o scorrendola per evidenziare ulteriore contenuto, si accetta la Cookie Policy e verranno impostati e raccolti i cookie. In caso di mancata accettazione dei cookie mediante abbandono della navigazione, eventuali cookie già registrati localmente nel Suo browser rimarranno ivi registrati ma non saranno più letti né utilizzati da noi fino ad una successiva ed eventuale accettazione della Policy. Lei avrà sempre la possibilità di rimuovere tali cookie in qualsiasi momento attraverso le modalità citate.